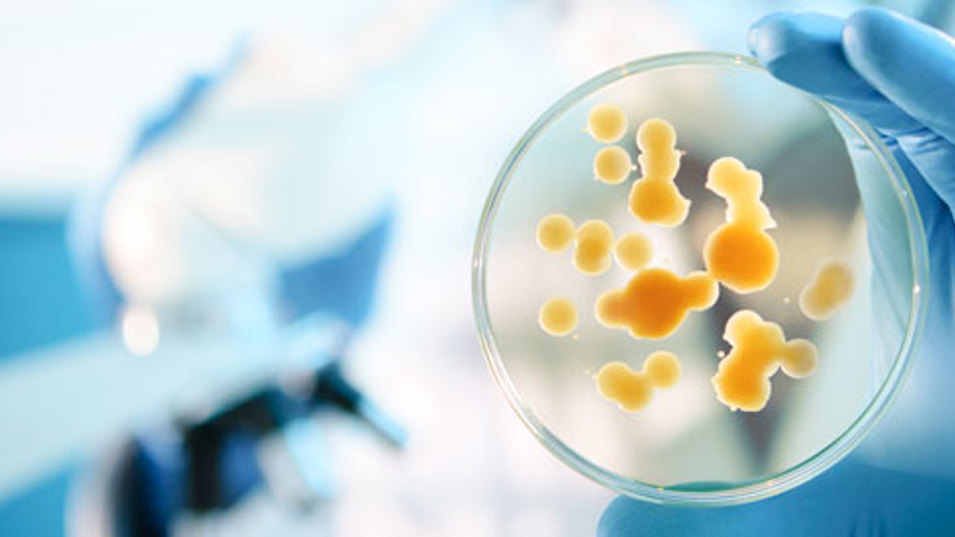
En bakteriekoloni i en petriskål i et laboratorium

Kampen for at undgå, at små organismer giver store problemer
Det Nationale Forskningscenter for Arbejdsmiljø - Af: Redaktionen - 01-11-2018
Sund fornuft, god tilrettelæggelse af arbejdet og styr på reglerne er vigtigt for at kunne håndtere potentielle udfordringer med mikroorganismer i arbejdsmiljøet.
Vi indånder hundredtusindvis af mikroorganismer hver dag. For nogle kan det måske være en skræmmende tanke. I de fleste tilfælde lever vi imidlertid i en fin symbiose med mikroorganismerne omkring os og inden i os. Og nogle af dem er oven i købet helt nødvendige for, at vi kan fungere ordentligt – dette gælder fx mange af bakterierne i vores tarmsystem.
Men i nogle tilfælde udgør bakterier og andre mikroorganismer en sundhedsrisiko. Enten fordi nogle af dem er sygdomsfremkaldende, eller fordi vi bliver udsat for rigtig mange af dem på én gang. Det gælder også i arbejdsmiljøet, selv om de fleste ikke tænker over det til dagligt.
Hvad er mikroorganismer?
Mikroorganismer kan fx være
- Bakterier
- Vira
- Svampe
- Nogle parasitter.
- I diskussioner om arbejdsmiljø kan mikrobiologi godt nogle gange være et område, som lever en lidt anonym tilværelse. Det handler måske om, at mikroorganismer ikke er synlige på samme måde, som nogle af de andre emner, man taler om, når man drøfter arbejdsmiljø på arbejdspladserne. Men det skal man ikke tage fejl af. Hvis man ikke forebygger og håndterer mulige risici, kan mikroorganismer i arbejdsmiljøet føre til alvorlige sygdomme, siger seniorforsker ved Det Nationale Forskningscenter for Arbejdsmiljø (NFA), Anne Mette Madsen.
En næsten umulig opgave at afdække alle risici
Udfordringen er at få afdækket de potentielle risici og tage stilling til, hvad der er skadeligt, og hvad der er harmløst. Men det er ikke altid så nemt.
- Som forsker vil man jo gerne systematisk identificere, klassificere og udvikle forebyggelsesstrategier for alle risici i arbejdsmiljøet. Men når det drejer sig om mikrobiologi, har vi at gøre med millioner af forskellige bakterier, svampe og andre mikroorganismer, og derfor er opgaven ret omfattende. Så der er rigtig meget, vi endnu ikke ved, siger Anne Mette Madsen.
Hun understreger dog samtidig, at den gennemsnitlige danske arbejdstager ikke skal gå rundt og bekymre sig.
Nogle typer af jobs er mere udsatte
- Generelt er det ikke noget, man skal gå rundt og være foruroliget over, hvis man ellers overholder almindelige regler for hygiejne. Men vi ved, at der er nogle typer af arbejde, hvor risikoen er højere for at blive udsat for arter, der kan være sygdomsfremkaldende, eller høje koncentrationer af mikroorganismer. Det gælder fx, når man arbejder i landbruget, på hospitaler og på plejecentre, med rengøring og renovation, i gartnerier og ved spildevandsanlæg. Det er også derfor vi har fokuseret vores forskning på nogle af disse områder, siger Anne Mette Madsen.
Mikroorganismer kan altså forekomme i meget forskellige typer af jobs, og man risikerer derfor også at blive udsat for meget forskellige udfordringer i arbejdsmiljøet. Alligevel er der nogle anvisninger og gode råd, som går på tværs uanset arbejdsmiljø.
God arbejdstilrettelæggelse og sund fornuft
Der er jo for det første nogle regler, der skal overholdes. Arbejde med sundhedsskadelige mikroorganismer skal fx anmeldes til Arbejdstilsynet og man skal gennemføre en biologisk arbejdspladsvurdering (APV). Derudover er der nogle vigtige grundprincipper, man bør overholde.
- Det bedste er selvfølgelig helt at fjerne farlige organismer i arbejdsmiljøet. Det kan ikke altid lade sig gøre, men nogle gange kan man komme langt med god planlægning af arbejdet, siger Anne Mette Madsen.
Som eksempel henviser hun til studier på gartnerier, der har vist, at hvis man fjerner agurkeplanter, inden de tørrer ud, så mindsker man risikoen for, at medarbejderne bliver udsat for høje koncentrationer af organisk støv med svampesporer og endotoksiner.
Arbejdspladser kan også nå langt ved at tilrettelægge arbejdet, så man afskærmer risikable processer og sørger for tilstrækkelig udluftning, udsugning og rengøring, så man undgår store mængder støv i arbejdsmiljøet.
God personlig hygiejne som fx hyppig håndvask og eventuelt et bad efter arbejdstid er også nødvendigt i nogle jobs. Og somme tider vil det også være nødvendigt at anvende personlige værnemidler som fx åndedrætsværn.
- Generelt er det vigtigt, når man arbejder med planter, dyr og mikroorganismer, at tage sin sunde fornuft med på arbejdet hver dag, ligesom arbejdspladsen skal afsætte tid og ressourcer til det nødvendige forebyggelsesarbejde, siger Anne Mette Madsen.
Fremtidens mikrobiologi i arbejdsmiljøet
Der findes ikke nogen generel afdækning af, hvor mange der er udsat for sygdomsfremkaldende mikroorganismer eller høje koncentrationer af mikroorganismer i det danske arbejdsmiljø. Derfor er det heller ikke muligt at sige, om der generelt er flere –personer, der er udsatte nu end tidligere i vores arbejdsmiljø. Men der er nogle overordnede tendenser, der formentlig vil komme til at påvirke området.
- Hvis klimaet ændrer sig, vil de mikrober, der er omkring os, også ændre sig. Så hvis det bliver varmere i Danmark, må vi generelt forvente, at der bliver lidt flere udfordringer med mikroorganismer, men de nærmere konsekvenser af dette er svære at forudsige, slutter Anne Mette Madsen.
Yderligere oplysninger
Seniorforsker Anne Mette Madsen, NFA
Hvor kan der især være risiko for kontakt med mikroorganismer?
Eksempler på arbejdsopgaver og -pladser, hvor medarbejdere har øget risiko for at blive udsat for mikroorganismer:
- Affald/spildevand (håndtering, service/reparation)
- Dyr (opdræt, transport, forarbejdning, pakning)
- Fugt i bygninger (ophold i bygningen, renovering/istandsættelse)
- Arbejde med mennesker (fx sygehuse, plejehjem/hjemmepleje, dag- og døgninstitutioner, tandlæger og læger)
- Mikroorganismer eller dele af dem (håndtering, produkter med levende mikroorganismer, produktion af noget, der stammer fra mikroorganismer, fx enzymer)
- Planter (dyrkning, forarbejdning, pakning)
- Støv (rengøring, saneringsarbejde)
Mikroorganismer i arbejdsmiljøet er derfor noget, som kan være relevant at være opmærksom på på rigtig mange arbejdspladser som fx:
- Biobrændselsanlæg
- Dyrehospitaler/dyrlæger
- Fiskeindustri
- Forarbejdning af korn, græsfrø og andre plantematerialer
- Gartnerier
- Hospitaler
- Håndværksfirmaer
- Institutioner - plejehjem, daginstitutioner o.lign.
- Kloakarbejde
- Laboratorier
- Landbrug – både planteavl og dyrehold
- Rengøringsfirmaer
- Rensningsanlæg
- Forbrændingsanlæg
- Renovationsfirmaer
- Slagterier.
Temanyhedsbrev om mikroorganismer i arbejdsmiljøet
Ovenstående artikel er en del af NFA's temanyhedsbrev om mikroorganismer i arbejdsmiljøet udsendt torsdag den 1. november 2018.
Læs hele temanyhedsbrevet her.